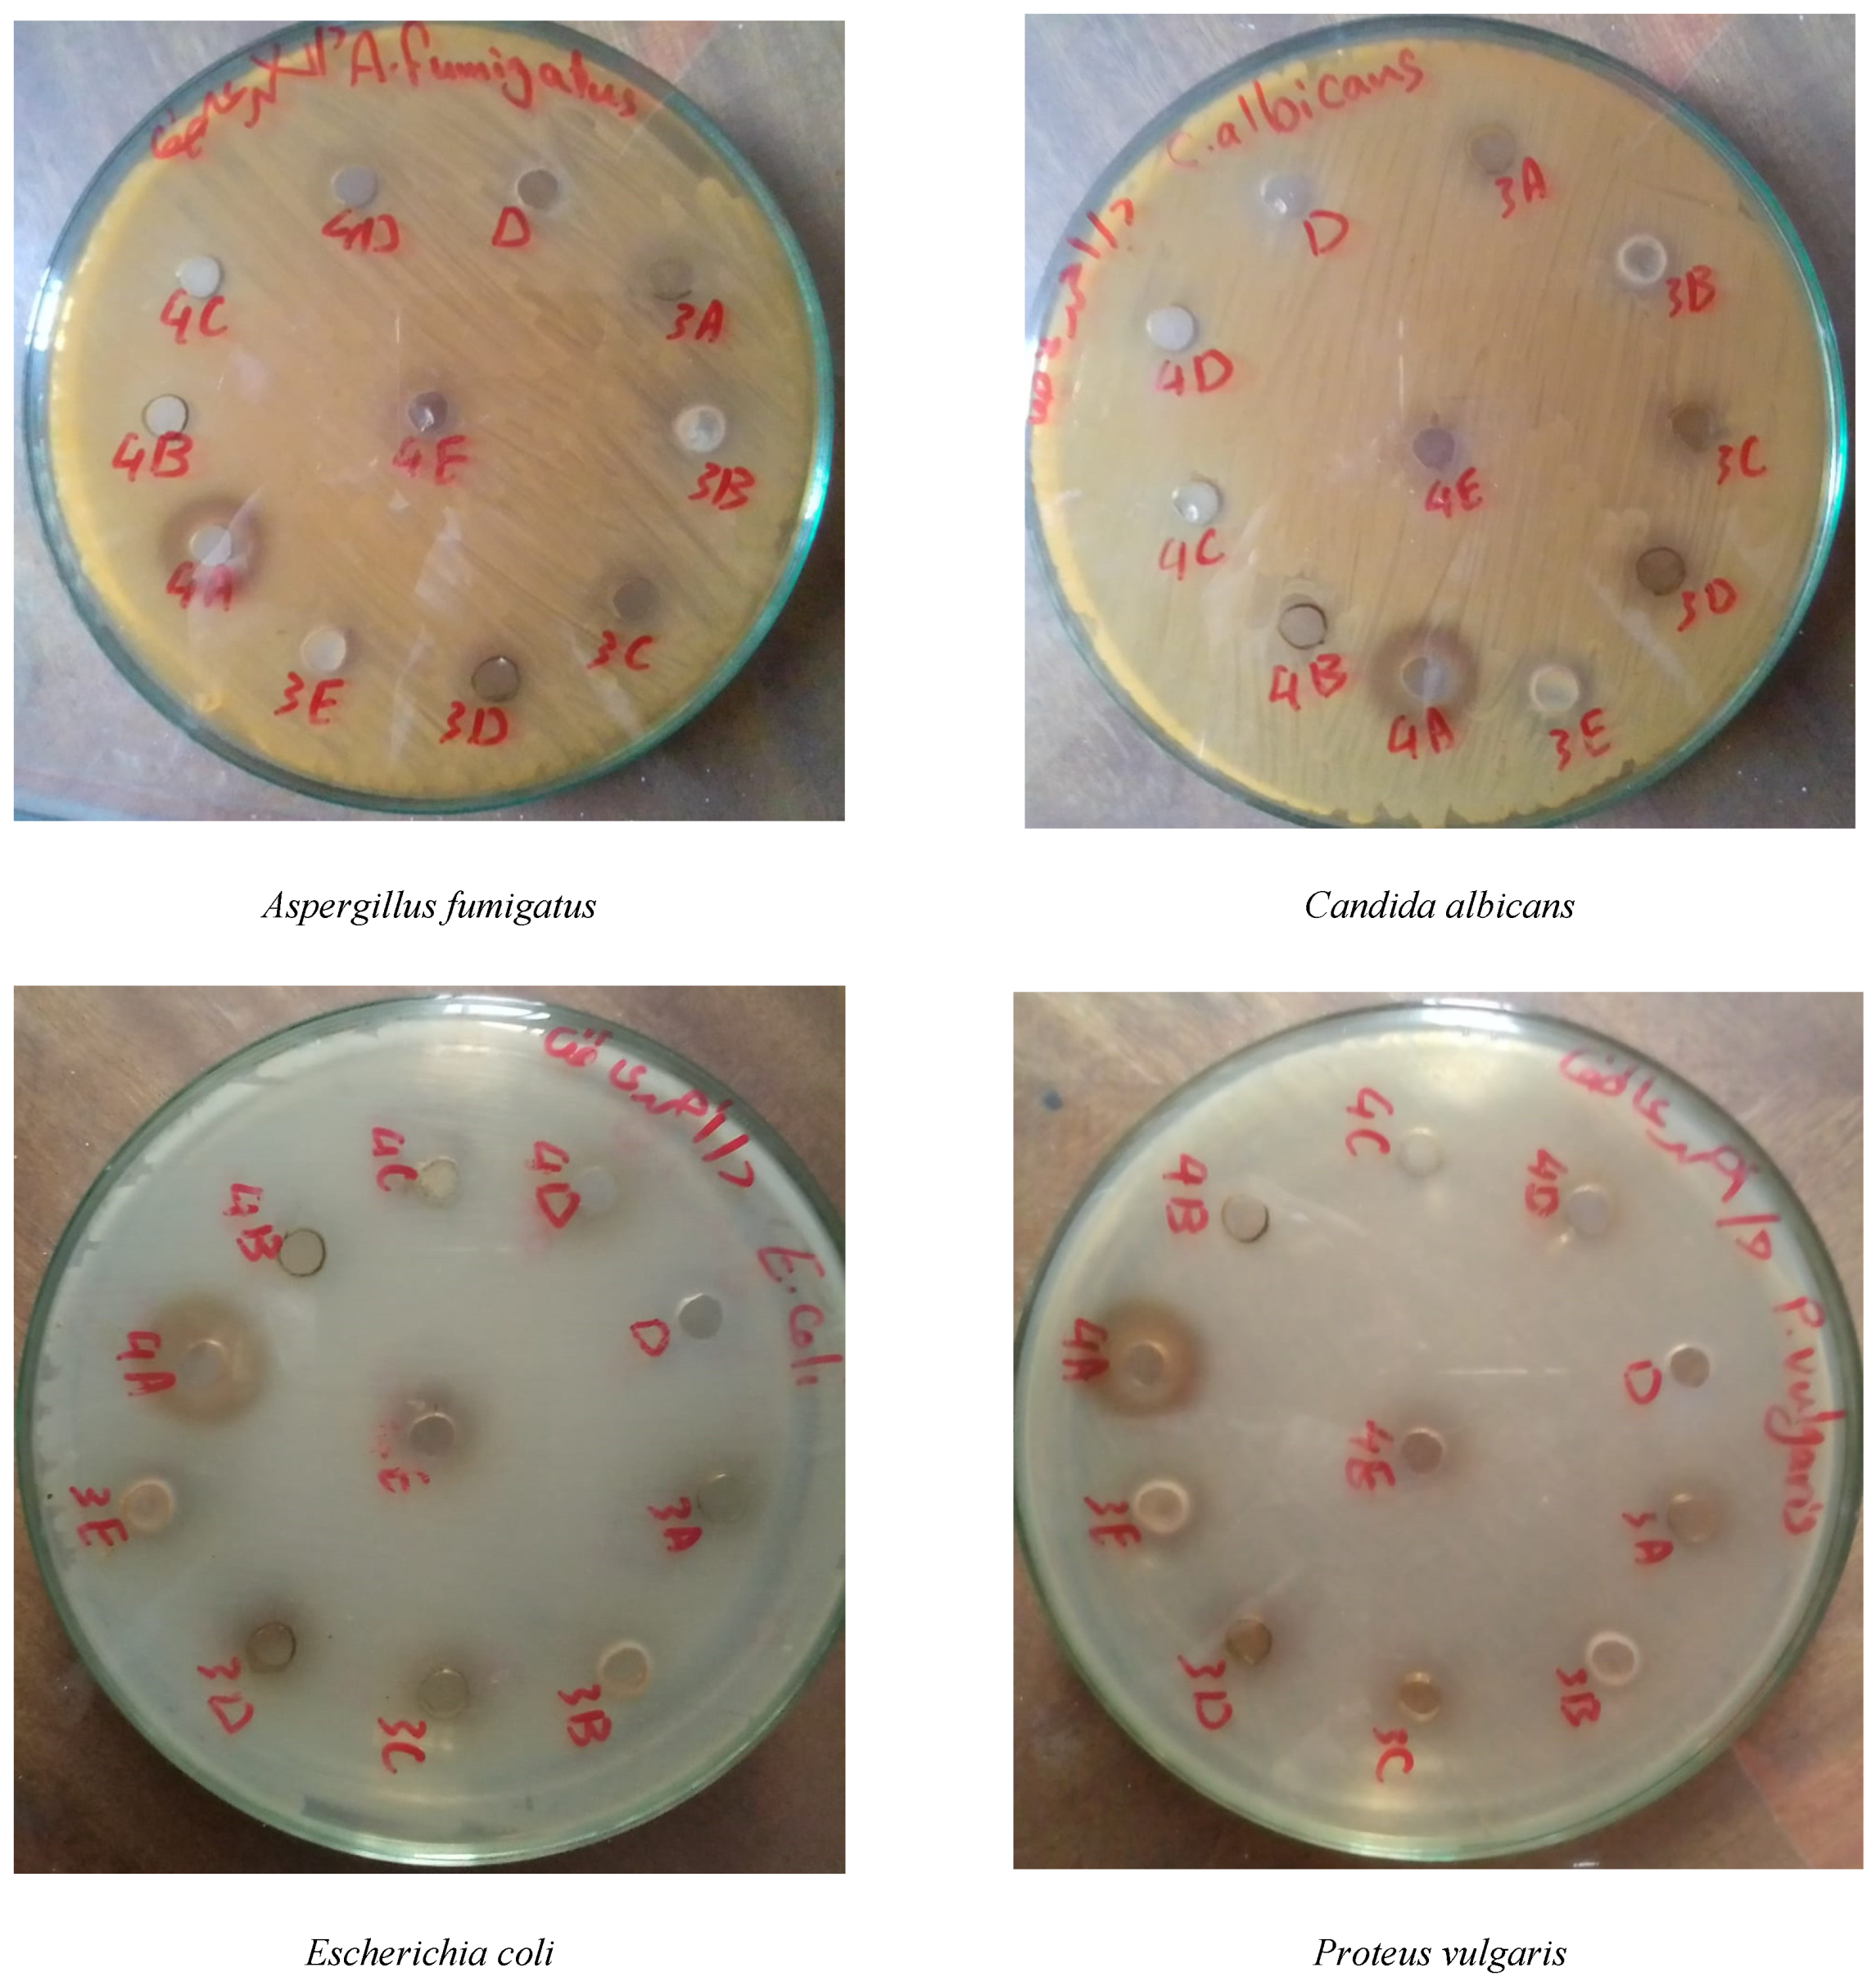
Agriculture 12 01925 g004a

Chemical and Nutritional Characterization of the Different Organs of Taif’s Rose (Rosa damascena Mill. var. trigintipetala) and Possible Recycling of the Solid Distillation Wastes in Taif City, Saudi Arabia
Abstract
1. Introduction
2. Materials and Methods
2.1. Plant Sampling
2.2. Sample Preparation and Quality Analysis
2.3. Phytochemical Analysis
2.3.1. Determination of Soluble Carbohydrates
2.3.2. Determination of Cardiac Glycosides
2.3.3. Determination of Total Flavonoid Contents (TFC)
2.3.4. Determination of the Total Phenolic Compounds
2.3.5. Estimation of Phytochemical Compounds Using HPLC
2.4. Biological Activity
2.4.1. Preparation of Extracts
2.4.2. Microorganisms Used
2.4.3. In Vitro Evaluation of the Antimicrobial Activity
2.5. Nutritional Analyses
2.5.1. Mineral Nutrients
2.5.2. Organic Nutrients
2.5.3. Nutritional Value
2.6. Statistical Analysis
3. Results and Discussion
3.1. Phytochemical Analysis
3.2. HPLC of Phytochemical Compounds
3.3. Biological Activity
3.3.1. Flower Extracts
3.3.2. Solid Distillation Waste Extracts
3.4. Nutritional Properties
3.4.1. Mineral Nutrients
3.4.2. Organic Nutrients
3.4.3. Nutritional Value
4. Conclusions
Author Contributions
Funding
Institutional Review Board Statement
Informed Consent Statement
Data Availability Statement
Acknowledgments
Conflicts of Interest
Appendix A
| Chemical Compound | Plant Organ | ||||
|---|---|---|---|---|---|
| Leaves | Stem | Flowers | SDW | ||
| Flavonoids concentration (mg g−1) | Quercetin | 11.09 | 12.61 | 20.10 | 2.69 |
| Apigenin | 4.59 | 23.83 | 47.02 | 11.25 | |
| Luteolin | 10.17 | 21.09 | 13.60 | ND | |
| Chrysoeriol | 19.20 | 45.19 | ND | 6.98 | |
| Rutin | 16.87 | 11.16 | 25.36 | ND | |
| Kaempferol | 21.59 | 27.55 | 19.10 | 9.68 | |
| Avicularin | ND | ND | 2.50 | 4.15 | |
| Phenolics concentration (mg g−1) | Gallic acid | 14.21 | 23.53 | 5.41 | ND |
| Ellagic acid | 7.94 | 14.90 | 11.69 | 7.25 | |
| Catechol | 13.70 | 6.59 | 8.60 | ND | |
| Resorcinol | 11.91 | 7.57 | ND | 8.79 | |
| Phloroglucinol | 6.24 | 0.93 | 1.69 | 3.45 | |
| Alkaloids concentration (mg g−1) | berbamine | 3.03 | 5.28 | ND | ND |
| jatrorrhizine | 5.10 | 5.83 | 5.60 | 4.26 | |
| palmatine | ND | 3.50 | ND | 3.44 | |
| reticuline | 1.88 | 8.50 | 5.30 | ND | |
| isocorydine | 1.60 | 4.70 | 9.11 | 4.77 | |
| boldine | ND | 0.64 | 4.79 | 3.56 | |
| Extract | Fungi | Bacteria | |||
|---|---|---|---|---|---|
| Gram- + ve Bacteria | Gram- − ve Bacteria | ||||
| Aspergillus fumigatus | Candida albicans | Bacillus subtilis | Escherichia coli | Proteus vulgaris | |
| Control | Ketoconazole | Gentamicin | Gentamicin | ||
| 17 | 20 | 26 | 30 | 17 | |
| Methanol | NA | NA | NA | 10 | 16 |
| Ethanol | NA | NA | 14 | 11 | 13 |
| Boiling water | NA | NA | NA | 13 | 18 |
| Cold water | NA | NA | NA | 12 | 18 |
| Warm water | NA | NA | 13 | NA | 14 |
| Extract | Fungi | Bacteria | |||
|---|---|---|---|---|---|
| Gram- + ve Bacteria | Gram- − ve Bacteria | ||||
| Aspergillus fumigatus | Candida albicans | Bacillus subtilis | Escherichia coli | Proteus vulgaris | |
| Control | Ketoconazole | Gentamicin | Gentamicin | ||
| 17 | 20 | 26 | 30 | 17 | |
| Methanol | 10 | 14 | 10 | 19 | NA |
| Ethanol | NA | NA | NA | NA | NA |
| Boiling water | NA | NA | NA | NA | NA |
| Cold water | NA | NA | NA | 14 | 12 |
| Warm water | NA | NA | 10 | 12 | 18 |
References
- Galal, T.M.; Al-Yasi, H.M.; Fawzy, M.A.; Abdelkader, T.G.; Hamza, R.Z.; Eid, E.M.; Ali, E.F. Evaluation of the Phytochemical and Pharmacological Potential of Taif’s Rose (Rosa damascena Mill var. trigintipetala) for Possible Recycling of Pruning Wastes. Life 2022, 12, 273. [Google Scholar] [PubMed]
- Tsanaktsidis, C.G.; Tamoutsidis, E.; Kasapidis, G.; Itziou, A.; Ntina, E. Preliminary results on attributes of distillation products of the rose Rosa damascene as a dynamic and friendly to the environment rural crop. APCBEE Procedia 2012, 1, 66–73. [Google Scholar] [CrossRef][Green Version]
- Nunes, H.; Miguel, M.G. Rosa damascena essential oils: A brief review about chemical composition and biological properties. Trends Pharmacol. Sci. 2017, 1, 111–128. [Google Scholar]
- Galal, T.M.; Majrashi, A.; Al-Yasi, H.M.; Farahat, E.A.; Eid, E.M.; Ali, E.F. Taif’s Rose (Rosa damascena Mill var. trigentipetala) Wastes Are a Potential Candidate for Heavy Metals Remediation from Agricultural Soil. Agriculture 2022, 12, 1319. [Google Scholar]
- Mileva, M.; Ilieva, Y.; Jovtchev, G.; Gateva, S.; Zaharieva, M.M.; Georgieva, A.; Dimitrova, L.; Dobreva, A.; Angelova, T.; Vilhelmova-Ilieva, N.; et al. Rose Flowers—A Delicate Perfume or a Natural Healer? Biomolecules 2021, 11, 127. [Google Scholar] [CrossRef]
- Al-Yasi, H.; Attia, H.; Alamer, K.; Hassan, F.; Ali, E.; Elshazly, S. Impact of drought on growth, photosynthesis, osmotic adjustment, and cell wall elasticity in damask rose. Plant Physiol. Biochem. 2020, 150, 133–139. [Google Scholar] [CrossRef]
- Pal, P.K. Evaluation, genetic diversity, recent development of distillation method, challenges and opportunities of Rosa damascena: A review. J. Essent. Oil Bear. Plants 2013, 16, 1–10. [Google Scholar] [CrossRef]
- Labban, L.; Thallaj, N. The medicinal and pharmacological properties of Damascene Rose (Rosa damascena): A review. Int. J. Herb. Med. 2020, 8, 33–37. [Google Scholar]
- Ghavam, M.; Afzali, A.; Manconi, M.; Bacchetta, G.; Manca, M.L. Variability in chemical composition and antimicrobial activity of essential oil of Rosa × damascena Herrm. from mountainous regions of Iran. Chem. Biol. Technol. Agric. 2021, 8, 22. [Google Scholar] [CrossRef]
- Hamza, R.Z.; Al-Yasi, H.M.; Ali, E.F.; Fawzy, M.A.; Abdelkader, T.G.; Galal, T.M. Chemical characterization of Taif rose (Rosa damascena Mill var. trigentipetala) waste methanolic extract and its hepatoprotective and antioxidant effects against cadmium chloride (CdCl2)-induced hepatotoxicity and potential anticancer activities against liver cancer cells (HepG2). Crystals 2022, 12, 460. [Google Scholar]
- Moein, M.; Etemadfard, H.; Zarshenas, M.M. Investigation of different Damask rose (Rosa damascena Mill.) oil samples from traditional markets in Fars (Iran); focusing on the extraction method. Trends Pharmacol. Sci. 2016, 2, 51–58. [Google Scholar]
- Alizadeh, Z.; Fattahi, M. Essential oil, total phenolic, flavonoids, anthocyanins, carotenoids and antioxidant activity of cultivated Damask Rose (Rosa damascena) from Iran: With chemotyping approach concerning morphology and composition. Sci. Hortic. 2021, 288, 110341. [Google Scholar] [CrossRef]
- Rusanov, K.; Kovacheva, N.; Atanassov, A.; Atanassov, I. Rosa damascena Mill., the oil-bearing Damask rose: Genetic resources, diversity and perspectives for molecular breeding. Floricul Ornam Biotech. 2009, 3, 14–20. [Google Scholar]
- Thakur, M.; Sharma, S.; Sharma, U.; Kumar, R. Study on effect of pruning time on growth, yield and quality of scented rose (Rosa damascena Mill.) varieties under acidic conditions of western Himalayas. J. Appl. Res. Med. Aromat. Plants 2019, 13, 100202. [Google Scholar] [CrossRef]
- Nasir, M.H.; Nadeem, R.; Akhtar, K.; Hanif, M.A.; Khalid, A.M. Efficacy of modified distillation sludge of rose (Rosa centifolia) petals for lead (II) and zinc (II) removal from aqueous solutions. J. Hazard. Mater. 2007, 147, 1006–1014. [Google Scholar] [CrossRef]
- Slavov, A.; Kiyohara, H.; Yamada, H. Immunomodulating pectic polysaccharides from waste rose petals of Rosa damascena Mill. Int. J. Biol. Macromol. 2013, 59, 192–200. [Google Scholar] [CrossRef] [PubMed]
- Galal, T.M.; Ali, E.F.; Eid, E.M.; Al-Yasi, H.M.; Magrashi, A.; Althobaiti, F.; Farahat, E.A. Evaluating the nutrient contents and nutritive value of Taif’s Rose (Rosa damascena Mill var. trigintipetala) wastes to be used as animal forage or soil organic fertilizers. Agriculture 2022, 12, 1481. [Google Scholar]
- Liu, W.; Chen, L.; Huang, Y.; Fu, L.; Song, L.; Wang, Y.; Bai, Z.; Meng, F.; Bi, Y. Antioxidation and active constituents analysis of flower residue of Rosa damascena. Chin. Herb. Med. 2020, 12, 336–341. [Google Scholar] [CrossRef]
- Slavov, A.; Panchev, I.; Kovacheva, D.; Vasileva, I. Physico-chemical characterization of water-soluble pectic extracts from Rosa damascena, Calendula officinalis and Matricaria chamomilla wastes. Food Hydrocoll. 2016, 61, 469–476. [Google Scholar] [CrossRef]
- Slavov, A.; Denev, P.; Panchev, I.; Shikov, V.; Nenov, N.; Yantcheva, N.; Vasileva, I. Combined recovery of polysaccharides and polyphenols from Rosa damascena wastes. Ind. Crops Prod. 2017, 100, 85–94. [Google Scholar] [CrossRef]
- Slavov, A.; Vasileva, I.; Stefanov, L.; Stoyanova, A. Valorization of wastes from the rose oil industry. Rev. Environ. Sci. Biotechnol. 2017, 16, 309–325. [Google Scholar] [CrossRef]
- Dodevska, T.; Vasileva, I.; Denev, P.; Karashanova, D.; Georgieva, B.; Kovacheva, D.; Yantcheva, N.; Slavov, A. Rosa damascena waste mediated synthesis of silver nanoparticles: Characteristics and application for an electrochemical sensing of hydrogen peroxide and vanillin. Mater. Chem. Phys. 2019, 231, 335–343. [Google Scholar] [CrossRef]
- Halawani, E.M. Antimicrobial activity of Rosa damascena petals extracts and chemical composition by gas chromatography-mass spectrometry (GC/MS) analysis. Afr. J. Microbiol. Res. 2014, 8, 2359–2367. [Google Scholar]
- Nayebi, N.; Khalili, N.; Kamalinejad, M.; Emtiazy, M. A systematic review of the efficacy and safety of Rosa damascena Mill. with an overview on its phytopharmacological properties. Complement. Ther. Med. 2017, 34, 129–140. [Google Scholar] [CrossRef] [PubMed]
- Davoodi, I.; Rahimi, R.; Abdollahi, M.; Farzaei, F.; Farzaei, M.H.; Memariani, Z.; Najafi, F. Promising effect of Rosa damascena extract on high-fat diet-induced nonalcoholic fatty liver. J. Tradit. Complement. Med. 2017, 7, 508–514. [Google Scholar] [CrossRef]
- Kumar, R.; Sharma, S.; Kaundal, M.; Sharma, S.; Thakur, M. Response of damask rose (Rosa damascena Mill.) to foliar application of magnesium (Mg), copper (Cu) and zinc (Zn) sulphate under western Himalayas. Ind. Crops Prod. 2016, 83, 596–602. [Google Scholar] [CrossRef]
- Pal, P.K.; Mahajan, M. Pruning system and foliar application of MgSO4 alter yield and secondary metabolite profile of Rosa damascena under rainfed acidic conditions. Front. Plant Sci. 2017, 8, 507. [Google Scholar] [CrossRef]
- Celano, R.; Piccinelli, A.L.; Pagano, I.; Roscigno, G.; Campone, L.; De Falco, E.; Russo, M.; Rastrelli, L. Oil distillation wastewaters from aromatic herbs as new natural source of antioxidant compounds. Food Res. Int. 2017, 99, 298–307. [Google Scholar] [CrossRef]
- Onursal, E.; Ekinci, K. Co-composting of rose oil processing waste with caged layer manure and straw or sawdust: Effects of carbon source and C/N ratio on decomposition. Waste Manag. Res. 2015, 33, 332–338. [Google Scholar] [CrossRef]
- Sadasivam, S.; Manickam, A. Biochemical Methods, 3rd ed.; New Age International Publishers: New Delhi, India, 2008. [Google Scholar]
- Solich, P.; Sedliaková, V.; Karlíček, R. Spectrophotometric determination of cardiac glycosides by flow-injection analysis. Anal. Chim. Acta 1992, 269, 199–203. [Google Scholar] [CrossRef]
- Tofighi, Z.; Ghazi, N.; Hadjiakhoondi, A.; Yassa, N. Determination of cardiac glycosides and total phenols in different generations of Securigera securidaca suspension culture. Res. J. Pharmacogn. 2016, 3, 25–31. [Google Scholar]
- Singleton, V.L.; Orthofer, R.; Rosa, M.B.T.; Raventós, L. Analysis of total phenols and other oxidation substrates and antioxidants by means of Folin-Ciocalteu reagent. Methods Enzymol. 1999, 299, 152–178. [Google Scholar]
- Schütz, K.; Kammerer, D.R.; Carle, R.; Schieber, A. Characterization of phenolic acids and flavonoids in dandelion (Taraxacum officinale WEB. Ex WIGG) root and herb by high performance liquid chromatography/electrospray ionization mass spectrometry. Rapid Commun. Mass Spectrom. 2005, 19, 179–186. [Google Scholar] [PubMed]
- Zheng, W.; Clifford, M.N. Profiling the chlorogenic acids of sweet potato (Ipomea batatas) from China. Food Chem. 2008, 106, 147–152. [Google Scholar] [CrossRef]
- Kandil, O.; Radwan, N.M.; Hassan, A.B.; Amer, A.M.; El-Banna, H.A.; Amer, W.M. Extracts and fractions of Thymus capitatus exhibit antimicrobial activities. J. Ethnopharmacol. 1994, 44, 19–24. [Google Scholar] [CrossRef]
- Das, M.M.; Deka, D.C. Evaluation of anticancer and antimicrobial activity of arborinine from Glycosmis pentaphylla. J. Biol. Act. Prod. Nat. 2017, 7, 131–139. [Google Scholar] [CrossRef]
- Abd El-Kader, H.A.; Sedde, S.R.; El-Shanawany, A.A. In vitro study of the effect of some medicinal plants on the growth of some dermatophytes. Assiut Vet. Med. J. 1995, 34, 36–42. [Google Scholar]
- Allen, S. Chemical Analysis of Ecological Materials; Blackwell Scientific Publications: London, UK, 1989. [Google Scholar]
- Chapman, H.D.; Pratt, P.F. Methods of Analysis for Soil, Plants and Water; University of California, Division of Agricultural Sciences: Los Angeles, CA, USA, 1961; pp. 233–234. [Google Scholar]
- Le Houérou, H.N. Chemical composition and nutritive value of browse in tropical West Africa. In Browse in Africa; Le Houérou, M.N., Ed.; ILCA: Addis Ababa, Ethiopia, 1980; pp. 261–289. [Google Scholar]
- Goering, H.K.; Van Soest, P.J. Forage fiber analysis (apparatus, reagents, procedures, and some applications). In Agricultural Handbook 379; United States Department of Agriculture: Washington, DC, USA, 1970. [Google Scholar]
- Van Soest, P.J.; Robertson, J.B.; Lewis, B.A. Methods of dietary fiber, neutral detergent fiber, and non-starch polysaccharides in relation to animal nutrition. J. Dairy Sci. 1991, 74, 3583–3597. [Google Scholar] [CrossRef]
- NRC (National Research Council). Nutrient Requirements of Beef Cattle, 7th ed.; updated 2000; The National Academies Press: Washington, DC, USA, 2000. [Google Scholar]
- NRC (National Research Council). Nutrient Requirements of Dairy Cattle, 8th ed.; NRC (National Research Council): Ottawa, ON, Canada, 2001. [Google Scholar]
- SPSS. IBM SPSS Statistics Version 21.0.; IBM Corp.: Armonk, NY, USA, 2012. [Google Scholar]
- Alzletni, H.; Galal, T.; Khalafallah, A. The Arable Weed Malva parviflora L., Ecophysiology and Phytochemistry; Lambert Academic Publishing Gmbh & Co.KG.: Saarbrücken, Germany, 2020; 220p, ISBN 978-3-613-97570-9. [Google Scholar]
- Tatke, P.; Satyapal, U.S.; Mahajan, D.C.; Naharwar, V. Phytochemical analysis, In-vitro antioxidant and antimicrobial activities of flower petals of Rosa damascena. Int. J. Pharmacogn. Phytochem. Res. 2015, 7, 246–250. [Google Scholar]
- Fathima, S.N.; Murthy, S.V. Cardioprotective effects to chronic administration of Rosa damascena petals in isoproterenol induced myocardial infarction: Biochemical, histopathological and ultrastructural studies. Biomed. Pharmacol. J. 2019, 12, 1155–1166. [Google Scholar] [CrossRef]
- Qureshi, M.N.; Stecher, G.; Sultana, T.; Abel, G.; Popp, M.; Bonn, G.K. Determination of carbohydrates in medicinal plants-comparison between TLC, mf-MELDI-MS and GC-MS. Phytochem. Anal. 2011, 22, 296–302. [Google Scholar] [CrossRef] [PubMed]
- Kimbel, J.C.; Carpenter, S.R. Effects of mechanical harvesting on Myriophyllum spicatum L. regrowth and carbohydrate allocation to roots and shoots. Aquat. Bot. 1981, 11, 121–127. [Google Scholar] [CrossRef]
- Aseeri, S.A.; Al-Yasi, H.M.; Galal, T.M. Aloe Species in the Kingdom of Saudi Arabia: Morphological, Phytochemical and Molecular Characterization; Lambert Academic Publishing Gmbh & Co.KG.: Saarbrücken, Germany, 2020; ISBN 978-620-2-66802-6. [Google Scholar]
- El-Bakry, A.A.; Hammad, A.; Galal, T.M.; Ghazi, M.; Rafat, F.A. Polymorphism in Calotropis procera: Variation of metabolites in populations from different phytogeographical regions of Egypt. Rend. Fis. Acc. Lincei 2014, 25, 461–469. [Google Scholar] [CrossRef]
- Dahat, Y.; Saha, P.; Mathew, J.T.; Chaudhary, S.K.; Srivastava, A.K.; Kumar, D. Traditional uses, phytochemistry and pharmacological attributes of Pterocarpus santalinus and future directions: A review. J. Ethnopharmacol. 2021, 276, 114127. [Google Scholar] [CrossRef]
- Sharma, A.; Gupta, H. Quercetin-a flavonoid. Chron. Young Sci. 2010, 1, 10–15. [Google Scholar]
- Adom, M.B.; Taher, M.; Mutalabisin, M.F.; Amri, M.S.; Abdul Kudos, M.B.; Sulaiman, M.W.; Sengupta, P.; Susanti, D. Chemical constituents and medical benefits of Plantago major. Biomed. Pharmacother. 2017, 96, 348–360. [Google Scholar] [CrossRef] [PubMed]
- Marzouk, M.S.; Soliman, F.M.; Shehata, I.A.; Rabee, M.; Fawzy, G.A. Flavonoids and biological activities of Jussiaea repens. Nat. Prod. Res. 2007, 21, 436–443. [Google Scholar] [CrossRef]
- Marlene, R.P.; Camila, K.P.; Cesar, M.B.; Evelyn, W.; Tânia, B.C.; Claudriana, L. Gallic acid and dodecyl gallate prevents carbon tetrachloride-induced acute and chronic hepatotoxicity by enhancing hepatic antioxidant status and increasing p53 expression. Biol. Pharmaceut. Bull. J. 2017, 40, 425–434. [Google Scholar]
- Yanni, Y.; Mengyao, W.; Yingjie, H.; Chuankai, L.; Xin, P.; Wen, Z.; Youyi, H. Appropriately raising fermentation temperature beneficial to the increase of antioxidant activity and gallic acid content in Eurotium cristatum-fermented loose tea. LWT-Food Sci. Technol. 2017, 82, 248–254. [Google Scholar]
- Algradi, A.M.; Liu, Y.; Yang, B.; Kuang, H. Review on the genus Brugmansia: Traditional usage, phytochemistry, pharmacology, and toxicity. J. Ethnopharmacol. 2021, 279, 113910. [Google Scholar] [CrossRef]
- Petruczynik, A. Analysis of alkaloids from different chemical groups by different liquid chromatography methods. Cent. Eur. J. Chem. 2012, 10, 802–835. [Google Scholar] [CrossRef]
- Li, T.S.C. Chinese and Related North American Herbs: Phytopharmacology and Therapeutic Values; CRC Press LLC: Boca Raton, FL, USA, 2000; 611p. [Google Scholar]
- Duke, J.A. Duke’s Handbook of Medicinal Plants of Latin America; CRC Press: Boca Raton, FL, USA; Taylor & Francis Group, LLC: Abingdon, UK, 2009; 962p. [Google Scholar]
- Metiner, K.; Özkan, O.; Seyyal, A.K. Antibacterial Effects of Ethanol and Acetone Extract of Plantago major L. on Gram Positive and Gram Negative Bacteria. Kafkas Univ. Vet. Fak. Derg. 2012, 18, 503–505. [Google Scholar]
- Saeed, R.; Ali, S.; Ullah, H.; Ullah, M.; Hassan, S.; Ahmed, S.; Akhwan, S. Phytochemical analysis and anti-microbial activities of Rosa indica collected from Kohat Pakistan. Am. J. Phytomed. Clin. Ther. 2014, 2, 1370–1377. [Google Scholar]
- Norziah, M.H.; Fezea, F.A.; Bhat, R.; Ahmad, M. Effect of extraction solvents on antioxidant and antimicrobial properties of fenugreek seeds (Trigonella foenum-graecum L.). Int. Food Res. J. 2015, 22, 1261–1271. [Google Scholar]
- Chang, K.H.; Wu, R.Y.; Chuang, K.C.; Hsieh, T.F.; Chung, R.S. Effects of chemical and organic fertilizers on the growth, flower quality and nutrient uptake of Anthurium andreanum, cultivated for cut flower production. Sci. Hortic. 2010, 125, 434–441. [Google Scholar] [CrossRef]
- Khater, E.S.G. Some physical and chemical properties of compost. Int. J. Waste Resour. 2015, 5, 172. [Google Scholar] [CrossRef]
- Roig, A.; Cayuela, M.L.; Sánchez-Monedero, M.A. An overview on olive mill wastes and their valorisation methods. Waste Manag. 2006, 26, 960–969. [Google Scholar] [CrossRef]
- Vasileva, V.; Naydenova, Y.; Stoycheva, I. Nutritive value of forage biomass from sainfoin mixtures. Saudi J. Biol. Sci. 2019, 26, 942–949. [Google Scholar] [CrossRef]
- Shaltout, K.H.; Galal, T.M.; El-Komy, T.M. Evaluation of the nutrient status of some hydrophytes in the water courses of Nile Delta, Egypt. Ecol. Mediterr. 2010, 36, 77–87. [Google Scholar] [CrossRef]
- Batajoo, K.K.; Shaver, R.D. Impact of nonfiber carbohydrate on intake, digestion, and milk production by dairy cows. J. Dairy Sci. 1994, 77, 1580–1587. [Google Scholar] [CrossRef]
- Kholif, A.E.; Gouda, G.A.; Morsy, T.A.; Salem, A.Z.M.; Lopez, S.; Kholif, A.M. Moringa oleifera leaf meal as a protein source in lactating goat’s diets: Feed intake, digestibility, ruminal fermentation, milk yield and compositio n, and its fatty acids profile. Small Rumin. Res. 2015, 129, 29–137. [Google Scholar] [CrossRef]
- Blümmel, M.; Updahyay, S.R.; Gautam, N.; Barma, N.C.D.; Abdul Hakim, M.; Hussain, M.; Joshi, A.K. Comparative assessment of food-fodder traits in a wide range of wheat germplasm for diverse biophysical target domains in South Asia. Field Crops Res. 2019, 236, 68–74. [Google Scholar] [CrossRef]
- Nelson, M.L.; Finley, J.W.; Scarnecchia, D.L.; Parish, S.M. Diet and forage quality of intermediate wheatgrass managed under continuous and short-duration grazing. J. Range Manag. 1989, 42, 474–477. [Google Scholar] [CrossRef]
- Coleman, S.W.; Rao, S.C.; Volesky, J.D.; Phillips, W.A. Growth and nutritive value of perennial C3 grasses in the southern Great Plains. Crop Sci. 2010, 50, 1070–1078. [Google Scholar] [CrossRef]
- Favre, J.R.; Castiblanco, T.M.; Combs, D.K.; Wattiaux, M.A.; Picasso, V.D. Forage nutritive value and predicted fiber digestibility of Kernza intermediate wheatgrass in monoculture and in mixture with red clover during the first production year. Anim. Feed. Sci. Technol. 2019, 258, 114298. [Google Scholar] [CrossRef]
- Heneidy, S.Z.; Halmy, M.W. The nutritive value and role of Panicum turgidum Forssk. in the arid ecosystems of the Egyptian desert. Acta Bot. Croat. 2009, 68, 127–146. [Google Scholar]
- Krachunov, I. Estimation of energy feeding value of forages for ruminants II. Energy prediction through crude fiber content. J. Mt. Agric. Balk. 2007, 10, 122–134. [Google Scholar]
- MAFF (Ministry of Agriculture, Fisheries, and Food). Energy Allowances and Feeding Systems for Ruminants; Technical Bulletin 33; Her Majesty’s Stationary Office: London, UK, 1975. [Google Scholar]
- NRC. Nutrient Requirements of Domestic Animals: Nutrient Requirement of Cheep, 6th ed.; Research Council Pamphelets No. 5; National Academic Sciences: Washington, DC, USA, 1985. [Google Scholar]
- Wu, G. Principles of Animal Nutrition; CRC Press: Boca Raton, FL, USA; London, UK; New York, NY, USA, 2018. [Google Scholar]
- El-Kady H Seasonal variation in phytomass and nutrient status of Phragmites australis along the water courses in the Middle Delta region. Taeckholmia 2002, 20, 123–138.
- Shaltout, K.H.; Galal, T.M.; El-Komy, T.M. Nutrients and heavy metals accumulation in the aboveground biomass of two perennial grasses along the water courses of Nile Delta, Egypt. In Proceedings of the Egyptian Journal of Botany, 3rd International Congress, Helwan, Egypt, 17–18 April 2013. [Google Scholar]
- Norton, B.W. Differences between species in forage quality. In Nutritional Limits to Animal Production from Pastures; Hacker, J.B., Ed.; CAB: Farnham Royal, UK, 1982; pp. 98–110. [Google Scholar]
- Cherian, G. A Guide to the Principles of Animal Nutrition; Open textbook library, Oregon State Open Educational Resources: Corvallis, IL, USA, 2020; 163p. [Google Scholar]
- Shoukry, M.M. An Actual Vision about the Availability of the Utilization of Water Hyacinth in Feeding Ruminants. In National Symposium on Water Hyacinth; Assiut University: Assiut, Egypt, 1992; pp. 75–92. [Google Scholar]
- Gill, K.S.; Omokanye, A. Spring triticale varieties forage yield, nutrients composition, and suitability for beef cattle production. J. Agric. Sci. 2016, 8, 1–14. [Google Scholar] [CrossRef]

| Organ | Carbohydrates | Cardiac Glycosides | Phenolics | Flavonoids | Alkaloids |
|---|---|---|---|---|---|
| % | mg Securiaside g−1 | mg GAE g−1 | mg RUE g−1 | mg AE g−1 | |
| Leaves | 2.09 ± 0.71 a | 3.61 ± 0.59 c | 9.81 ± 1.79 b | 6.33 ± 1.52 b | 9.43 ± 1.17 a |
| Stem | 0.85 ± 0.08 b | 4.84 ± 0.63 b | 5.45 ± 1.55 c | 7.46 ± 1.16 b | 5.70 ± 1.21 b |
| Flower | 0.66 ± 0.08 b | 7.66 ± 0.20 a | 16.33 ± 0.10 a | 10.90 ± 0.20 a | 3.44 ± 0.14 c |
| Flower wastes | 0.56 ± 0.04 b | 5.63 ± 0.16 b | 14.36 ± 2.11 a | 9.80 ± 0.26 a | 2.36 ± 0.10 c |
| F-value | 19.73 *** | 38.54 *** | 55.75 *** | 13.98 *** | 23.98 *** |
| Organ | N | P | K | Ca | Mg | Na |
|---|---|---|---|---|---|---|
| mg kg−1 | ||||||
| Leaves | 98.01 ± 3.86 ab | 6.58 ± 0.54 a | 101.54 ± 10.89 b | 173.93 ± 26.03 | 85.43 ± 14.90 | 167.64 ± 19.09 ab |
| Stem | 138.73 ± 16.49 a | 6.53 ± 1.77 a | 174.57 ± 17.20 a | 165.46 ± 24.28 | 96.12 ± 17.01 | 136.15 ± 15.17 b |
| Flower | 71.70 ± 5.31 b | 1.49 ± 0.19 b | 117.10 ± 2.01 ab | 147.54 ± 17.20 | 91.32 ± 12.01 | 198.08 ± 12.34 a |
| Distillation wastes | 81.58 ± 6.23 b | 2.24 ± 0.17 b | 102.13 ± 13.11 b | 135.55 ± 13.93 | 89.83 ± 11.73 | 195.18 ± 9.32 a |
| F-value | 4.55 * | 24.83 *** | 5.5 ** | 0.96 | 0.22 | 4.01 * |
| Organ | Total Protein (%) | NFE (%) | Ash (%) | Fat (%) | Crude Fiber (%) | ADF (%) | ADL (%) | NDF (%) |
|---|---|---|---|---|---|---|---|---|
| Leaves | 6.13 ± 1.69 ab | 59.85 ± 9.96 a | 11.67 ± 2.69 c | 0.50 ± 0.05 ab | 21.86 ± 3.48 | 22.88 ± 7.11 a | 3.93 ± 1.12 a | 38.21 ± 7.88 |
| Stem | 8.66 ± 2.27 a | 52.63 ± 13.81 a | 7.34 ± 1.75 d | 0.14 ± 0.01 c | 31.33 ± 3.81 | 24.17 ± 5.16 a | 2.49 ± 0.49 ab | 36.51 ± 3.31 |
| Flower | 4.71 ± 0.49 b | 53.92 ± 5.15 a | 18.74 ± 2.34 b | 0.36 ± 0.05 b | 22.26 ± 2.29 | 15.54 ± 1.41 ab | 1.71 0.09 b | 38.51 ± 3.36 |
| Distillation wastes | 5.13 ± 0.38 b | 28.39 ± 4.78 b | 29.39 ± 2.87 a | 0.57 ± 0.05 a | 36.52 ± 1.58 | 14.23 ± 1.75 b | 3.60 ± 0.31 a | 34.56 ± 1.53 |
| F-value | 4.31 * | 5.28 ** | 62.75 *** | 14.93 *** | 2.71 | 2.96 * | 2.85 * | 0.46 |
| Organ | DCP (%) | TDN (%) | DE (Mcal/kg) | ME (Mcal/kg) | NE (Mcal/kg) | GE (Mcal/kg) |
|---|---|---|---|---|---|---|
| Leaves | 2.71 ± 0.44 ab | 58.28 ± 1.87 ab | 2.68 ± 0.37 a | 2.20 ± 0.31 a | 1.10 ± 0.01 a | 385.58 ± 8.24 b |
| Stem | 4.52 ± 0.16 a | 56.18 ± 1.82 b | 2.61 ± 0.42 a | 2.14 ± 0.42 a | 1.07 ± 0.03 a | 412.61 ± 9.59 a |
| Flower | 0.86 ± 0.05 b | 59.19 ± 3.13 a | 2.25 ± 0.19 a | 1.85 ± 0.16 a | 0.93 ± 0.06 a | 354.33 ± 6.62 c |
| Distillation wastes | 1.24 ± 0.35 b | 59.05 ± 2.32 a | 1.23 ± 0.08 b | 1.23 ± 0.08 b | 0.62 ± 0.04 b | 324.11 ± 9.13 d |
| F-value | 4.31 * | 5.28 ** | 62.75 *** | 14.93 *** | 2.71 | 2.96 * |
| Component | Significance |
|---|---|
| Inorganic nutrients (N, P, Na, K, Ca, Mg) | Soil amendments, organic fertilizers |
| Organic nutrients (carbohydrates, proteins, fats, fibers) | Animal forage, industrial application |
| Nutritional components (DCP, TDN, GE, ME, NE) | Animal forage |
| Secondary metabolites (cardiac glycosides, flavonoids, alkaloids, phenolics) | Medicinal purposes (e.g., cancer-preventative properties, antioxidant, anti-inflammatory, and antimicrobial), pharmaceutical industry. |
Publisher’s Note: MDPI stays neutral with regard to jurisdictional claims in published maps and institutional affiliations. |
© 2022 by the authors. Licensee MDPI, Basel, Switzerland. This article is an open access article distributed under the terms and conditions of the Creative Commons Attribution (CC BY) license (https://creativecommons.org/licenses/by/4.0/).
Share and Cite
Ali, E.F.; Al-Yasi, H.M.; Majrashi, A.; Farahat, E.A.; Eid, E.M.; Galal, T.M. Chemical and Nutritional Characterization of the Different Organs of Taif’s Rose (Rosa damascena Mill. var. trigintipetala) and Possible Recycling of the Solid Distillation Wastes in Taif City, Saudi Arabia. Agriculture 2022, 12, 1925. https://doi.org/10.3390/agriculture12111925
Ali EF, Al-Yasi HM, Majrashi A, Farahat EA, Eid EM, Galal TM. Chemical and Nutritional Characterization of the Different Organs of Taif’s Rose (Rosa damascena Mill. var. trigintipetala) and Possible Recycling of the Solid Distillation Wastes in Taif City, Saudi Arabia. Agriculture. 2022; 12(11):1925. https://doi.org/10.3390/agriculture12111925
Chicago/Turabian StyleAli, Esmat F., Hatim M. Al-Yasi, Ali Majrashi, Emad A. Farahat, Ebrahem M. Eid, and Tarek M. Galal. 2022. "Chemical and Nutritional Characterization of the Different Organs of Taif’s Rose (Rosa damascena Mill. var. trigintipetala) and Possible Recycling of the Solid Distillation Wastes in Taif City, Saudi Arabia" Agriculture 12, no. 11: 1925. https://doi.org/10.3390/agriculture12111925
APA StyleAli, E. F., Al-Yasi, H. M., Majrashi, A., Farahat, E. A., Eid, E. M., & Galal, T. M. (2022). Chemical and Nutritional Characterization of the Different Organs of Taif’s Rose (Rosa damascena Mill. var. trigintipetala) and Possible Recycling of the Solid Distillation Wastes in Taif City, Saudi Arabia. Agriculture, 12(11), 1925. https://doi.org/10.3390/agriculture12111925

